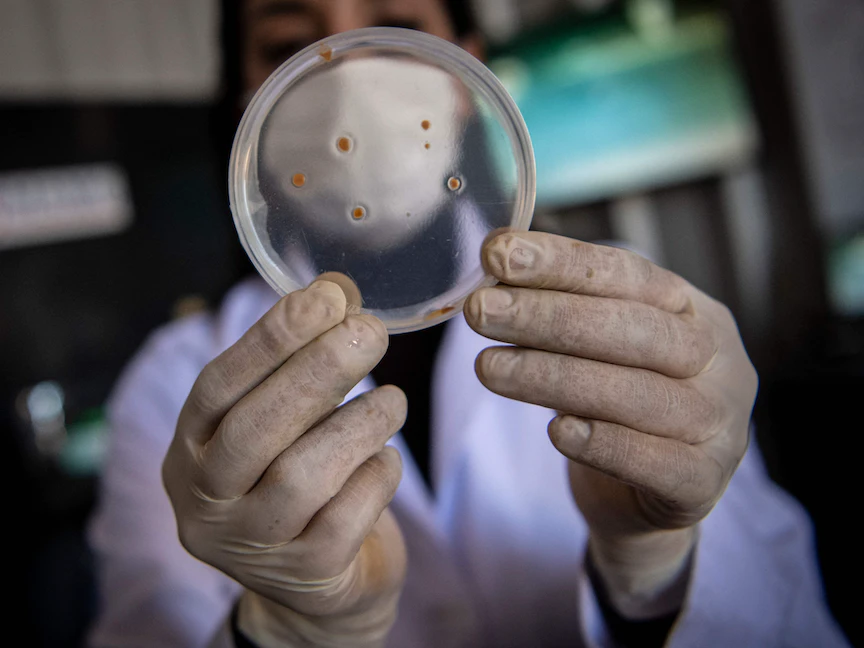

تغطي البكتيريا الأغشية المبطنة لأمعائك، وتنشئ نظاماً بيئياً متناهي الصغر يطلق عليه الميكروبيوم. ورغم أننا حقاً لا نلحظ وجودها، فهي تؤدي دوراً بالغ الأهمية في الحفاظ على صحتك، بل يمكن لها التأثير في حالتك المزاجية وسلوكك أيضاً.
ولا عجب في أن ما تطعم به نظام الميكروبيوم يمكن أن يكون له بالغ الأثر على صحته. وكلما كان هذا النظام أكثر صحة، صرت أنت كذلك أكثر صحة.
وتتمثل وسيلة الحصول على ميكروبيوم صحي في إحداث التوازن في التغذية بين أنواع البكتيريا المختلفة الموجودة في أمعائك، والتي يبلغ عددها ألف نوع تقريباً.
وتوجد طريقتان للحفاظ على هذا التوازن، وهما مساعدة هذه الميكروبات الموجودة بالفعل لتنمو بإعطائها الطعام الذي تحبه (بريبيوتيك) وإضافة الميكروبات الحية مباشرة إلى نظامك (بروبيوتيك).
البريبيوتيك
البريبيوتيك هي ألياف نباتية متخصصة. مثلها مثل المخصبات التي تعمل على تحفيز نمو البكتيريا في الأمعاء.
وتوجد البريبيوتيك في العديد من الفواكه والخضراوات، خاصة تلك التي تحتوي على الكربوهيدرات المعقدة، مثل الألياف والنشا المقاوم.
هذه الكربوهيدرات لا يمكن لجسمك هضمها لذلك تمر من خلال الجهاز الهضمي لتصبح غذاءً للبكتيريا وغيرها من الميكروبات.
الشركات المنتجة للمكملات الغذائية تقوم بدورها بتسويق منتجات معينة لحالات صحية محددة مثل صحة العظام وإدارة الوزن، مدعيةً أن مكوناتها تعزز نمو أنواع معينة من البكتيريا.
البروبيوتك
تختلف البروبيوتك في أنها تحتوي على كائنات دقيقة حية، عادة ما تكون فصائل من البكتيريا تزيد مباشرة من عدد الميكروبات الصحية في معدتك.
مثل البريبيوتيك، يمكنك تناول البروبيوتك من خلال الطعام والمكملات الغذائية، وأكثر الأطعمة التي تحتوي على البروبيوتك شيوعاً هو الزبادي.
يتم تصنيع الزبادي بتخمير اللبن بأنواع مختلفة من البكتيريا، والتي تترك في المنتج النهائي.
ومن الأطعمة الأخرى التي تنتج من تخمر البكتيريا الكرنب المخلل، فهو يعد أيضاً مصدراً جيداً للبروبيوتك.
وتحتوي مكملات البروبيوتك أيضاً على كائنات دقيقة حية. قد تتضمن جرعة واحدة فصيلة محددة من الميكروب أو مزيج من الميكروبات.
مثل ما يحدث مع مكملات البريبيوتيك، تقوم شركات مكملات البروبيوتك بتسويق منتجات لحالات محددة، مثل متلازمة القولون المتهيج.
أنواع المكملات
من الأمور التي عليك أن تفهمها بخصوص المكملات أن هناك أنواعاً كثيرة جداً منها. مثلاً، هناك نوع شائع الاستخدام من البكتيريا وهو الملبنة الحمضة.
ولكن هناك أكثر من 120 فصيلة من الملبنة الحمضة، تُستخدم دزينة منها على الأقل باعتبارها بروبيوتك.
والأكثر من ذلك أن هناك أنواعاً أخرى متعددة من البكتيريا، ولكل منها عشرات الفصائل، وهو ما يؤدي إلى العديد من الأنواع المتاحة من البروبيوتك إلى الحد الذي يثير الدوار.
وحتى عندما تنتقي نوعاً من البكتيريا، فإن الكمية الموجودة ضمن المكمل يمكن أن تختلف من علامة تجارية لأخرى.
عند تناول البروبيوتك، ابحث عن الحالة المرضية التي ترغب في علاجها، وانتقِ البروبيوتك بناءً على تلك الحالة.
ضع في حسبانك كذلك أنه بينما قد يبدو البروبيوتك واعداً في علاج حالة ما، فلا تزال الأبحاث العلمية على الأرجح في مراحل مبكرة.
*هذا المحتوى من "مايو كلينيك".




